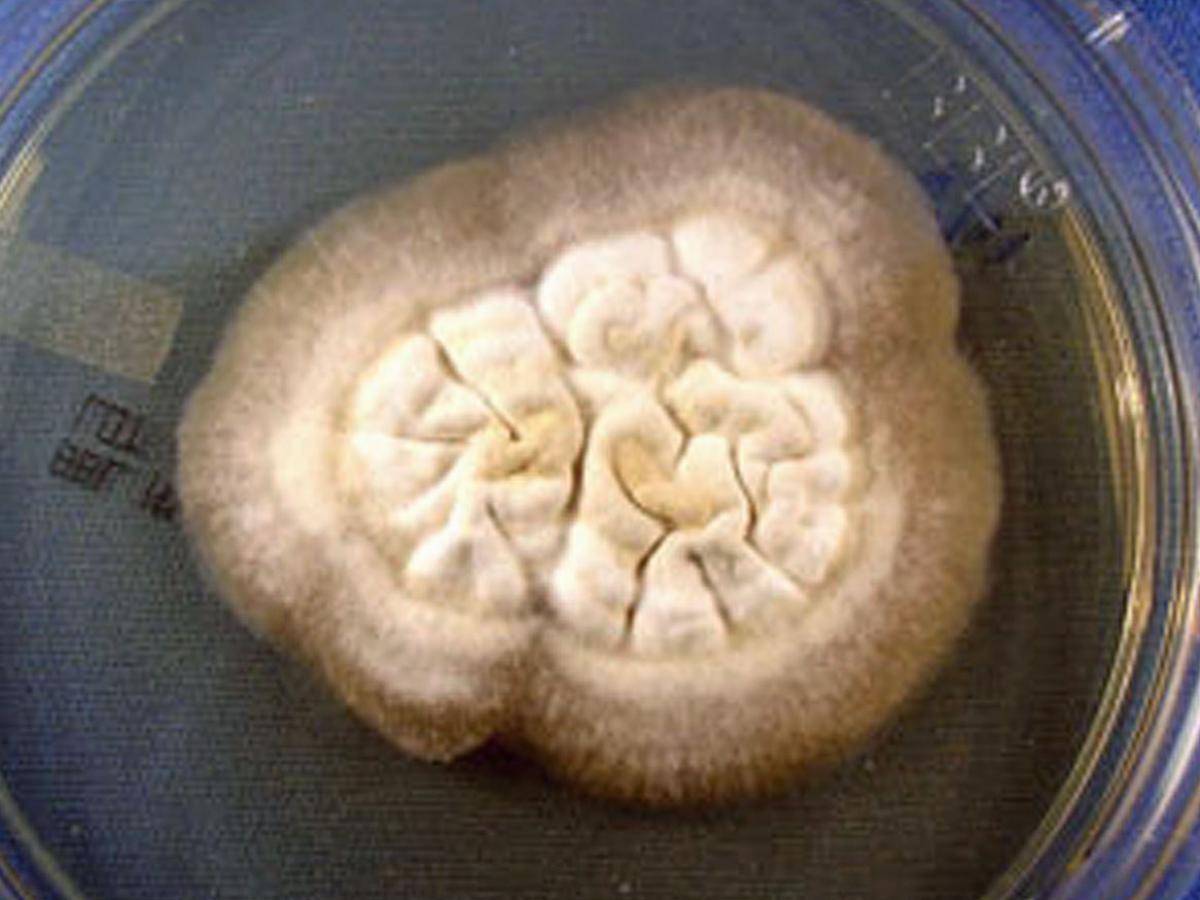
Culture

Status message
Correct! Excellent, you have really done well. Please find additional information below.
Unknown 8 = Blastomyces dermatitidis
Direct microscopy (H&E staining): H&E stain of lung tissue containing abundant broad-based budding yeast cells morphologically consistent with Blastomyces dermatitidis. (1000X magnification)
Culture: Typical colony morphology of Blastomyces dermatitidis. Thallus develops slowly, developing a fine white to tan aerial mycelium. Reverse is tan to brown in colour.
Microscopy: Calcofluor white stain of mould phase growth at 30C. Septate hyphae bearing round or pear-shaped terminal conidia attached to conidiophores of varying lengths or directly on the hyphae are observed. (600X magnification).

Calcofluor white stain of yeast phase growth at 36C. Large, globose, yeastlike cells are apparent, some with broad bases. (1000X magnification).
Comment: Blastomycosis is a chronic granulomatous and suppurative disease having a primary pulmonary stage that is frequently followed by dissemination to other body sites, chiefly the skin and bone. Although the disease was long thought to be restricted to the North American continent, in recent years autochthonous cases have been diagnosed in Africa, Asia and Europe.
In most individuals pulmonary lesions are asymptomatic and are not detected until the infection has spread to other organs. Others develop symptoms after an incubation period of 3-15 weeks. In most cases blastomycosis is indolent in onset and patients present with chronic symptoms such as cough, fever, malaise and weight loss. The lesions become more extensive, with continued suppuration and eventual necrosis and cavitation. Occasional patients present with an acute onset of infection, with development of high fever, chills, productive cough, myalgia, arthralgia and pleuritic chest pain. Often these patient appear to recover after 2-12 weeks of symptoms, but some will return months later with lesions at other sites. Other patients with acute onset will fail to recover and will develop a chronic chest infection or disseminated infection. Chest radiographic findings are variable and are not diagnostic.
I would like to thank Jon Biehle, Dept. of Pathology, Creighton University, Omaha, NE, USA. for providing all the images.
About Blastomyces Back to virtual assessment